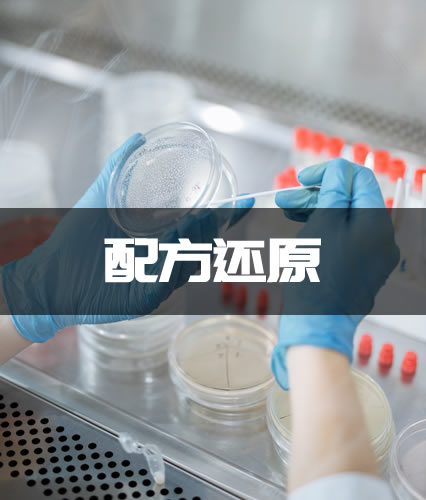

我们能为您解决哪些问题?
知分析专注于为生产制造型企事业单位提供一体化的产品配方技术研发服务,2019年成功申请高新技术企业认定,2020年度荣获上海市科技型中小企业技术创新资金项目支持,2021年在上海股交所成功挂牌。
通过赋能各领域生产型企业,致力于推动新材料研发升级,为产品性能带来突破性的成效。本着以分析研究为使命,坚持以客户需求为导向,通过高性价比和严谨的技术服务,助力企业产品生产研发、性能改进效率。
服务领域覆盖高分子材料、精细化学品、生物医药、节能环保、日用化学品等领域。坚持秉承“服务,不止于分析!”的服务理念,在提供不同产品配方技术研发服务的同时,为确保客户合法权益不受侵害,还提供专利申报等知识产权服务。您的信任,是我们的坚守动力和追求。

知分析
知分析